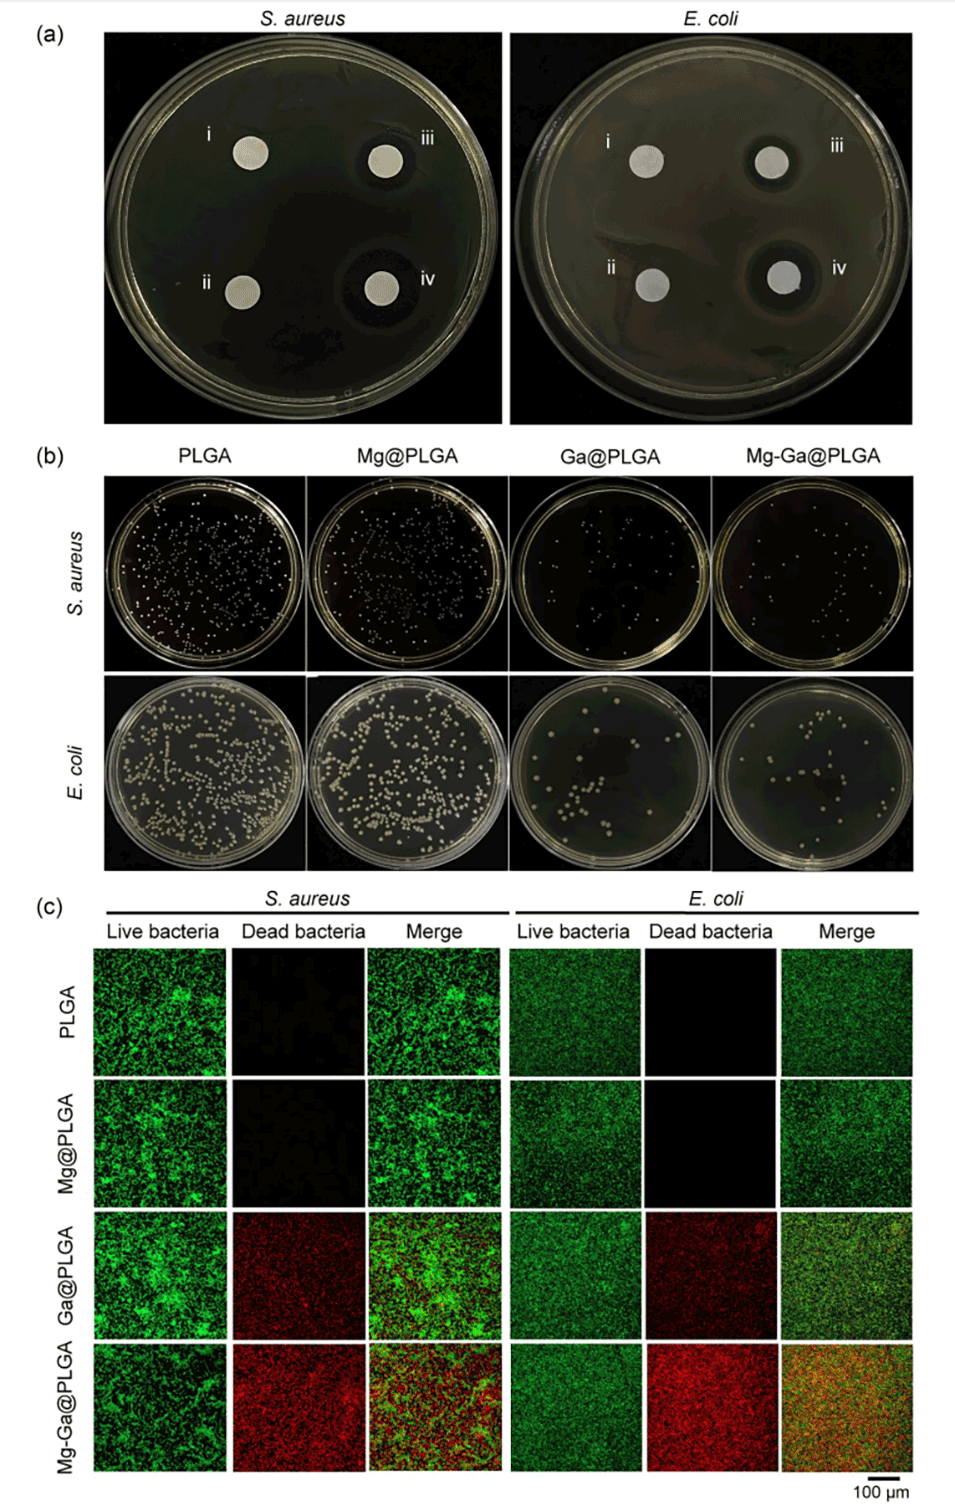

骨缺损通常由感染、肿瘤切除和机械创伤引起,严重影响患者生活质量。传统的骨移植治疗方法存在供体不足、感染风险、免疫排斥等问题,同时还面临高成本和多次手术的挑战。为实现有效的骨再生,理想的生物材料需具备良好的生物相容性,能够招募干细胞或祖细胞至损伤部位,并提供有利于成骨分化的微环境。此外,感染风险是骨缺损修复中的重要挑战,因此开发兼具成骨和抗菌功能的生物材料成为研究重点。

近期,军事科学院军事医学研究院环境医学与作业医学研究所王新兴主任、天津医科大学口腔医院陈刚教授采用改良的水包油包水乳液法制备了镁和镓共负载的PLGA微球,这些微球能有效促进成骨分化、抑制破骨细胞分化,并具有抗菌效果,展现出治疗感染性骨缺损的巨大潜力。相关研究以“Magnesium and gallium-coloaded microspheres accelerate bone repair via osteogenesis and antibiosis”为题目,发表在期刊《Bio-Design and Manufacturing》上。
本文要点:
1、本研究制备了镁(Mg2+)和镓(Ga3+)共负载的聚乳酸-羟基乙酸共聚物(PLGA)微球(Mg-Ga@PLGA),可填充不规则骨缺损并显示出良好的生物安全性。
2、在体外试验中,Mg-Ga@PLGA不仅促进了成骨分化,还抑制了破骨细胞分化,并表现出抗菌活性。在体内测试中,Mg-Ga@PLGA展现出很强的原位成骨能力。
4、镁通过激活RAS/RAF/MEK/ERK和Bmp2/Runx2信号通路来促进成骨细胞的分化,而镓则通过抑制破骨细胞活性和抗菌作用改善骨修复效果,为伴有感染风险的骨缺损修复提供了一种新型、有效的治疗策略。
Mg-Ga@PLGA微球的制备步骤如下:
1、材料准备:准备聚乳酸-羟基乙酸共聚物(PLGA)、二氯甲烷(DCM)、聚乙烯醇(PVA)、硫酸镁(MgSO4)和硝酸镓(Ga(NO3)3)。
2、油相制备:将100毫克PLGA缓慢滴入4毫升DCM中,形成油相(O)。
3、水相制备:将20%的MgSO4和2%的Ga(NO3)3粉末分散在1% PVA中,形成水相(W2)。
4、内水相制备:将1毫升超纯水作为内水相(W1),逐滴加入油相中,并搅拌形成W1/O混合物。
5、乳液形成:将W1/O溶液快速倒入100毫升的W2中,继续搅拌,形成复合乳液。
6、蒸发和离心:搅拌24小时,直到DCM完全蒸发。然后将混合物离心,去除上清液,收集沉淀。
7、清洗和干燥:对沉淀进行清洗后,再次离心以收集微球,最后进行冷冻干燥,得到Mg-Ga@PLGA微球。
在骨缺损修复中使用Mg-Ga@PLGA微球的优势如下:
1、促进成骨:Mg-Ga@PLGA微球能够显著促进成骨细胞(如MC3T3-E1细胞)的分化,增强成骨相关蛋白的表达(如Runx2和Bmp2),从而加速新骨的形成。
2、抑制破骨:微球中的镓离子(Ga3+)具有抑制破骨细胞(如骨髓来源巨噬细胞,BMMs)分化的作用,减少骨吸收,维持骨密度。
3、抗菌效果:Ga3+对多种细菌(如金黄色葡萄球菌和大肠杆菌)具有显著的抗菌活性,能够降低感染风险,特别是在骨缺损修复过程中,预防感染对愈合的负面影响。
4、良好的生物相容性:Mg-Ga@PLGA微球在体外和体内实验中表现出良好的生物相容性,未引起明显的细胞毒性,支持细胞的增殖和存活。
5、可填充不规则骨缺损:微球形态使其能够作为注射材料或冻干粉末,灵活填充不规则形状的骨缺损区域。
6、缓释特性:微球能够缓慢释放Mg2+和Ga3+,维持局部生物活性成分的浓度,提供一个有利的微环境,促进细胞的迁移和分化。
7、优异的骨愈合能力:在动物实验中,Mg-Ga@PLGA微球在骨缺损模型中表现出最佳的骨愈合效果,骨体积和骨密度均优于其他对照组。
8、多功能性:结合了促进成骨、抑制破骨和抗菌的多重功能,该微球在复杂骨缺损的修复中具有更高的治疗潜力。
综上所述,Mg-Ga@PLGA微球通过其生物活性成分的协同作用,在骨缺损修复中展现出巨大潜力,能够有效促进骨愈合并降低感染风险。

图1.Mg-Ga@PLGA微球的特性。

图2.Mg-Ga@PLGA微球的生物相容性。

图3.Mg-Ga@PLGA在体外引起细胞凋亡。

图4.Mg-Ga@PLGA对MC3T3-E1细胞成骨分化相关蛋白表达水平的影响。

图5.Mg-Ga@PLGA对MC3T3-E1细胞成骨分化的影响。
图6.微球的抗菌性能评估。

图7.植入PLGA、Mg@PLGA、Ga@PLGA和Mg-Ga@PLGA微球后12周骨形成的评估。

图8.体内蛋白质的成骨作用评估。
论文链接:https://doi.org/10.1631/bdm.2300253






